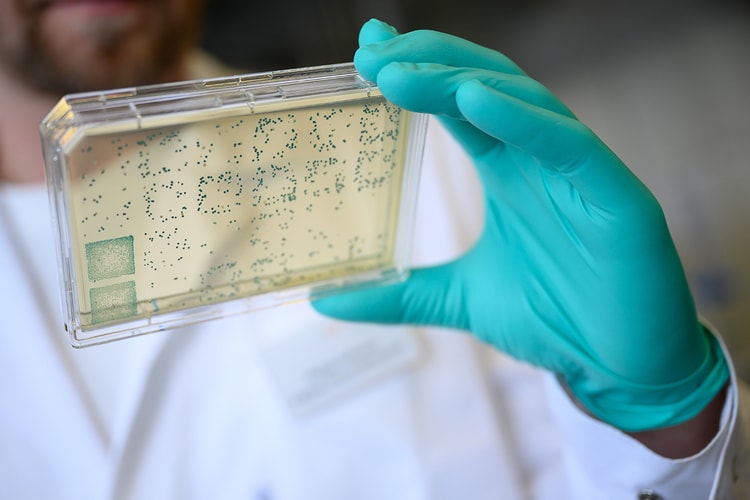
科學家發現人類基因仍在「持續演化」之證據

从大理石纹到 Paisley 印花,盘点 2020-2021 赛季最佳球衣设计
背后的细节巧思你都了解吗?
深受新冠疫情影响的体育赛事,仍会在未来很长一段时间内告别山呼海啸般的现场加油声,不过竞技体育的激情与魅力,依然会为全球体育迷带去勇气。尽管东京奥运会和欧洲杯的比赛被迫推后一年,但以 NBA 和欧洲五大联赛为首的体育赛事正在不断完善复赛制度。
不同于刚刚结束总冠军争夺的 NBA,欧洲主流足球联赛均于上个月开启了 2020/21 赛季的争夺,而随着各支球队主场、客场、第二客场球衣和特别版球衣的全面揭晓,我们也特别从中挑选出了 10 套最具特色的设计,为大家详细解构其背后的灵感巧思。
Arsenal 2020-21 赛季客场球衣 (adidas)
Hypebeast
英超豪门 Arsenal 新赛季客场球衣的灵感,来源于海布里(Highbury)球场著名的大理石厅,虽然球队早已在 2006 年搬去了新的酋长球场,但保留下来的海布里东看台依旧是球队辉煌历史的见证者。该球衣在设计上采用了特别定制的手绘图案,并以白色、栗色和黑色还原了大理石的自然纹理,该花纹也与大理石厅中安放球队传奇 Herbert Chapman 雕塑的大理石基座完美呼应。设计师希望用这种传承的方式,激励新一代球员和球迷,将海布里曾经的荣耀带到酋长球场,同时也共同推动俱乐部前进。
Manchester City 2020-21 赛季第二客场球衣 (PUMA)
Hypebeast
作为英伦摇滚文化的发源地之一,曼彻斯特见证了无数传奇乐队的诞生,这其中就包括 Manchester City 的死忠球迷 Oasis,而球队也在今年的第二客场球衣中注入了 Paisley 腰果花图案,从而向这座城市的音乐和足球基因致敬。Paisley 元素不仅是上世纪末英伦摇滚艺术家的代名词,以及 1960 年代青年文化的主要标志,更是今年最火爆的潮流元素之一。除此之外,设计师还借鉴了球队队徽上兰开夏玫瑰和曼彻斯特三条河流的图案,以马卡兰色调进一步聚焦于球队的历史与基因。
Real Madrid 2020-21 赛季第二客场球衣 (adidas)
Hypebeast
时隔三年重夺西甲冠军的 Real Madrid,在 Zinedine Zidane 的带领下开启了新赛季的征程。球队在 2020-21 赛季的第二客场球衣中,大胆采用了抢眼的黑粉配色,其正面的黑、灰色巴洛克风格印花,灵感源自马德里随处可见的巴洛克式建筑和 Azulejo 瓷砖画,而球队 Logo、赞助商广告和 adidas 胜利三条纹则采用了鲜明的粉色呈现,诠释了这座历史名城所独有的风格韵味与时尚美学。
Borussia Dortmund 2020-21 赛季主场球衣 (PUMA)
Hypebeast
有着「大黄蜂」之称的 Borussia Dortmund,拥有着最为疯狂和死忠的球迷,而球队新赛季主场球衣的灵感便来源于俱乐部深厚的球迷文化。该球衣除了保留俱乐部的黄色主调外,还通过黑色几何印花致敬了 Westfalenhallen 地铁站的「指南针」元素,对于许多球迷而言,这座地铁站是他们每次前往球队主场 Signal Iduna Park 观赛的必经之处。拥有锐利外观的黑色印花,不仅让球衣更显动感与醒目,更贴合了 Borussia Dortmund 近年来在足坛掀起的「青春风暴」。
AC Milan 2020-21 赛季客场球衣 (PUMA)
Hypebeast
时尚之都意大利米兰,是一座拥有大量典雅建筑的国际化大都市,而 AC Milan 全新客场球衣便以 MUDEC 博物馆的浓厚艺术内涵为创意,以此展现这座城市深厚的建筑文化底蕴。在这座博物馆里收藏了来自全球的艺术瑰宝,体现了多元文化在米兰的汇聚与交融,而该客场球衣正面的几何图案,正是重现了 MUDEC 博物馆的建筑特征,旨在表达俱乐部和广大球迷对于这座城市的自豪与归属感。
Inter Milan 2020-21 赛季主场球衣 (Nike)
Hypebeast
米兰城另一支拥有百年历史的豪门球队 Inter Milan,则在新赛季主场球衣中对俱乐部传统色彩进行了一次大胆且激进的诠释。受到上世纪 80 年代米兰设计师们开创性作品的启发,该球衣将传统的蓝黑条纹改成了锯齿状的几何形态,鲜明的蓝、黑色条纹沿着球衣蜿蜒而下,不仅参考了后现代主义的设计美学,也让人联想到曾经出现在球队 Logo 中的「Biscione 龙形蛇」图案,该图案也一直是米兰城的象征性元素之一。
Juventus 2020-21 赛季主场球衣 (adidas)
Hypebeast
同样对球队传统设计做摩登演绎的,还有统治意甲近十年的 Juventus。「斑马军团」在 2020-21 赛季主场球衣从当代艺术中汲取灵感,以艺术笔刷的形式重新演绎俱乐部经典黑白条纹,辅以金色细节象征球队的王者地位。作为球队文化不可或缺的一部分,黑白条纹一直是俱乐部与球迷之间的纽带,也连结起球队的过往和现在,而该球衣则在保留球队基因的同时,展现了球队创新求变的精神。
Paris Saint-Germain 2020-21 赛季客场球衣 (Nike)
Hypebeast
作为最具时尚感的足球俱乐部之一,Paris Saint-Germain 在新赛季通过主客场球衣同时使用「Hechter 条纹」的形式,来为俱乐部的 50 岁生日庆生。这个由时尚设计师兼俱乐部前主席 Daniel Hechter 所创造的红色条纹,从 1973 年开始便成为了 PSG 乃至整个巴黎最特殊的标志之一。PSG 新赛季的客场球衣还原了球队在 1995-96 赛季的白色球衣,当时球队获得了俱乐部历史上第一个欧洲冠军:欧洲优胜者杯;而带有纽扣的经典 Polo 领设计,则再一次凸显了球队所独有的时尚基因。
Olympique de Marseille 2020-21 赛季客场球衣 (PUMA)
Hypebeast
法甲球队 Olympique de Marseille 在新赛季的球衣设计中,汲取了这座城市的建筑和文化特色,其白色主场球衣深受建筑大师 Le Corbusier 的野兽派作品马赛公寓(Unité d’habitation)影响,而海军蓝色的客场球衣则通过印花图案展现了马赛老港(Vieux-Port)的特色古迹,象征着马赛人的团结和荣耀,不仅呼应了俱乐部「马赛,战斗继续」的主题活动,也再次向球迷强调了这座城市的起源和身份认同。
Red Star FC 2020-21 赛季主场球衣 (adidas)
Hypebeast
最后登场的 Red Star FC 大家可能并不熟悉,但这支球队堪称法国足坛「最特殊」的一家俱乐部:球队创始人 Jules Rimet 曾是国际足联的第三任主席,并创立了全球最具影响力的体育比赛世界杯,此外它也是唯一一家被 adidas 允许自主设计球衣的法国俱乐部。Red Star FC 的全新球衣委托了伦敦足球文化创意团队 Acid FC 负责设计,不仅从球队主场 Stade Bauer 的旧物件吸取灵感,更以法式茹伊印花(Toile de Jouy)形式呈现了能够代表俱乐部历史的人和物,而胸前广告赞助商「VICE」同样也是这件球衣的一大特色。
从大理石印花到 Paisley 花纹……运动品牌在今年的设计中加入了更多大胆的元素,足坛三巨头中的领头羊 adidas 依旧保持着较高的设计水准;一直被人诟病设计单调的 Nike 开始做出新的尝试;而设计向来大胆的 Puma 也展现出了进一步攻占足球市场的野心。
那么除了上述球衣之外,还有哪些让你觉得眼前一亮的新赛季球衣呢?欢迎在评论处与大家分享。